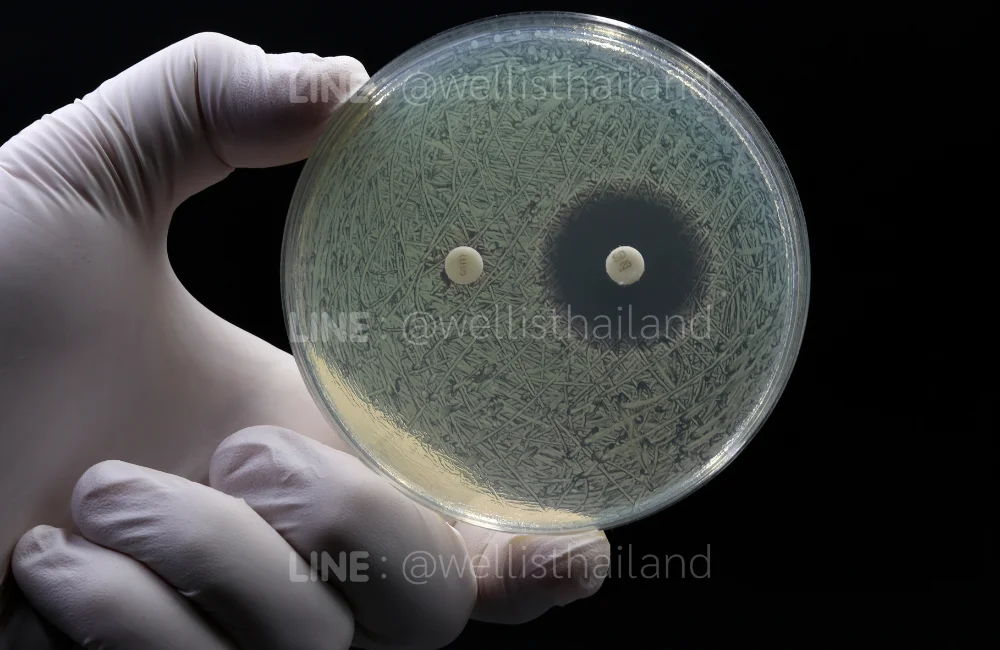
รู้จักเชื้อดื้อยา (Antimicrobial Resistance) คืออะไร

เชื้อดื้อยา เจาะลึกเทคโนโลยีเครื่องฆ่าเชื้อโรค ตัวช่วยป้องกันที่เหนือกว่า
ปัจจุบันโลกกำลังเผชิญหน้ากับภัยคุกคามทางสุขภาพที่เงียบแต่น่ากลัวยิ่งกว่าการระบาดของไวรัสชนิดใหม่ นั่นคือ เชื้อดื้อยา หรือ Antimicrobial Resistance (AMR) ที่กำลังกลายเป็นปัญหาใหญ่ของระบบสาธารณสุขโลก การป้องกันและต่อสู้กับเชื้อดื้อยาจึงต้องอาศัยเทคโนโลยีใหม่ที่ทันสมัยและมีประสิทธิภาพสูง โดยเฉพาะเครื่องฆ่าเชื้อโรคที่สามารถทำลายเชื้อโรคได้อย่างครอบคลุมทั้งในอากาศและบนพื้นผิวสัมผัส
รู้จักเชื้อดื้อยา (Antimicrobial Resistance) คืออะไร?
เชื้อดื้อยา หรือ AMR เป็นสภาวะที่เชื้อโรคต่างๆ เช่น แบคทีเรีย ไวรัส เชื้อรา และปรสิต พัฒนาความสามารถในการต้านทานยาที่ใช้รักษาโรค ทำให้ยาปฏิชีวนะ ยาต้านไวรัส และยาต้านเชื้อราที่เคยมีประสิทธิภาพกลายเป็นไร้ผล เชื้อโรคเหล่านี้สามารถปรับตัวและกลายพันธุ์เพื่อเอาตัวรอดจากการรักษา ส่งผลให้การติดเชื้อเป็นโรคที่รักษายากหรือรักษาไม่ได้
องค์การอนามัยโลก (WHO) ระบุว่า เชื้อดื้อยา เป็นหนึ่งในภัยคุกคามสุขภาพสาธารณะที่ร้ายแรงที่สุด 10 อันดับแรกของโลก โดยในปี 2019 มีผู้เสียชีวิตจากการติดเชื้อดื้อยาถึง 1.27 ล้านคนทั่วโลก และคาดว่าจะเพิ่มขึ้นเป็น 10 ล้านคนต่อปีภายในปี 2050 หากไม่มีการจัดการที่เหมาะสม
ทำไมสุขอนามัยทั่วไปอาจไม่พอสำหรับ “เชื้อดื้อยา”?
การรักษาความสะอาดด้วยวิธีทั่วไปเช่น การล้างมือด้วยสบู่ การใช้แอลกอฮอล์เจล หรือการเช็ดพื้นผิวด้วยน้ำยาทำความสะอาดธรรมดา อาจไม่เพียงพอในการกำจัดเชื้อดื้อยาที่มีความแข็งแกร่งและสามารถอยู่รอดได้ในสภาพแวดล้อมที่หลากหลาย
ความน่ากลัวของเชื้อดื้อยา (AMR) ที่ทนต่อยาปฏิชีวนะ
เชื้อดื้อยาประเภท MRSA (Methicillin-resistant Staphylococcus aureus) และ VRE (Vancomycin-resistant Enterococci) สามารถอยู่รอดบนพื้นผิวได้นานหลายสัปดาห์ แม้จะใช้น้ำยาฆ่าเชื้อทั่วไป เชื้อเหล่านี้มีเยื่อหุ้มเซลล์ที่แข็งแรงและมีกลไกการป้องกันตัวเองที่ซับซ้อน ทำให้ยาปฏิชีวนะมาตรฐานไม่สามารถทำลายได้
การแพร่กระจายของเชื้อโรคในอากาศและบนพื้นผิวสัมผัส (Airborne & Surface Transmission)
เชื้อดื้อยาสามารถแพร่กระจายได้หลายช่องทาง โดยเฉพาะผ่านอากาศเมื่อมีการไอ จาม หรือพูด และสามารถเกาะติดบนพื้นผิวสัมผัสต่างๆ เช่น ลูกบิดประตู โต๊ะ เก้าอี้ อุปกรณ์อิเล็กทรอนิกส์ และเครื่องใช้ส่วนตัว การป้องกันจึงต้องครอบคลุมทั้งการทำความสะอาดอากาศและการฆ่าเชื้อบนพื้นผิววัตถุ
จุดเสี่ยงในบ้านและที่ทำงานที่มักถูกมองข้าม
สถานที่ที่มีความเสี่ยงสูงต่อการแพร่กระจายเชื้อดื้อยา ได้แก่ ห้องน้ำ ครัว พื้นที่รับประทานอาหาร ห้องนอน และออฟฟิศที่มีการใช้งานร่วมกัน นอกจากนี้ยังมีจุดที่มักถูกมองข้าม เช่น ช่องแอร์ พัดลม ม่าน และสิ่งของที่ใช้สัมผัสบ่อย เช่น รีโมทคอนโทรล มือถือ และคีย์บอร์ด
ผลกระทบและอันตรายของเชื้อดื้อยา
ผลกระทบของเชื้อดื้อยามีทั้งในระดับบุคคลและสังคม ในระดับบุคคล การติดเชื้อดื้อยาทำให้ระยะเวลาการรักษานานขึ้น ค่าใช้จ่ายในการรักษาสูงขึ้น และมีความเสี่ยงต่อการเสียชีวิตเพิ่มขึ้น สำหรับระดับสังคม เชื้อดื้อยาส่งผลต่อระบบสาธารณสุข เศรษฐกิจ และการพัฒนาทางการแพทย์
กลุ่มเสี่ยงสูงที่ต้องระวังเชื้อดื้อยาเป็นพิเศษ ได้แก่ เด็กเล็กและทารก ผู้สูงอายุ ผู้ป่วยที่มีภูมิคุ้มกันต่ำ ผู้ป่วยโรคเรื้อรัง และผู้ที่ได้รับการรักษาในโรงพยาบาลเป็นระยะเวลานาน
รู้จัก “เครื่องฆ่าเชื้อโรค” นวัตกรรมหยุดการแพร่กระจายเชื้อที่ต้นตอ
เครื่องฆ่าเชื้อโรคสมัยใหม่เป็นเทคโนโลยีที่พัฒนามาเพื่อจัดการกับปัญหาเชื้อดื้อยาอย่างจริงจัง โดยใช้หลักการทำลายโครงสร้างของเชื้อโรคในระดับโมเลกุล แทนการพึ่งพายาปฏิชีวนะหรือสารเคมีเพียงอย่างเดียว
หลักการทำงานเทคโนโลยีฆ่าเชื้อโรค
เครื่องฆ่าเชื้อโรคในอากาศและพื้นผิวที่ใช้เทคโนโลยีประจุไฮดรอกซิล (Hydroxyl) เป็นนวัตกรรมที่โดดเด่นในการต่อสู้กับเชื้อดื้อยา โดยการปล่อยประจุพลาสม่าที่สามารถทำลายเยื่อหุ้มเซลล์ของเชื้อโรคได้อย่างมีประสิทธิภาพ ไม่ว่าเชื้อนั้นจะดื้อต่อยาหรือไม่ก็ตาม อย่างเครื่องฆ่าเชื้อโรค Wellis Air ใช้เทคโนโลยีนี้ในการผลิตไฮดรอกซิลจากน้ำมันโอเลฟินส์ ทำให้ปลอดภัยต่อมนุษย์และสัตว์เลี้ยง
เลือกและใช้เครื่องฆ่าเชื้อโรคอย่างไร ให้ปลอดภัยและได้ผลสูงสุด
การเลือกเครื่องฆ่าเชื้อโรคที่เหมาะสมต้องคำนึงถึงหลายปัจจัย เพื่อให้สามารถป้องกันเชื้อดื้อยาได้อย่างมีประสิทธิภาพ
การเลือกเครื่องให้เหมาะกับขนาดพื้นที่: ห้องนอน ออฟฟิศ หรือคลินิก
สำหรับพื้นที่ขนาดเล็กถึงปานกลาง เช่น ห้องนอน ห้องนั่งเล่น หรือออฟฟิศขนาดไม่เกิน 50-100 ตารางเมตร เครื่องฆ่าเชื้อโรค Wellis Air เครื่องเดียวสามารถครอบคลุมได้เพียงพอ
ตำแหน่งการวางเครื่องเพื่อประสิทธิภาพที่ดีที่สุด
ตำแหน่งการวางเครื่องฆ่าเชื้อโรคควรอยู่ในตำแหน่งที่อากาศสามารถถ่ายเทได้ทั่วห้อง โดยแนะนำให้วางในระดับโต๊ะ ห่างจากผนังและสิ่งกีดขวาง เพื่อให้ประจุไฮดรอกซิลสามารถกระจายไปทั่วพื้นที่ได้อย่างมีประสิทธิภาพ หลีกเลี่ยงการวางใกล้หน้าต่างหรือประตูที่เปิดอยู่ เพื่อป้องกันการสูญเสียประจุ
ข้อควรระวังและความปลอดภัยในการใช้งาน
แม้ว่าเทคโนโลยีไฮดรอกซิลจะปลอดภัยต่อมนุษย์ แต่เทคโนโลยีอื่น เช่นเครื่องฟอกอากาศ UV-C และเครื่องฟอกอากาศโอโซน อาจมีข้อจำกัดและความเสี่ยงในการใช้งาน การเลือกเครื่องที่ได้รับการรับรองความปลอดภัยจากหน่วยงานที่น่าเชื่อถือ เช่น มาตรฐานอุตสาหกรรม หรือ มอก.
การบำรุงรักษาเพื่อให้เครื่องทำงานได้เต็มประสิทธิภาพ
การบำรุงรักษาเครื่องฆ่าเชื้อโรค Wellis Air นั้นง่ายกว่าเครื่องฟอกอากาศทั่วไป เนื่องจากไม่มีไส้กรองที่ต้องเปลี่ยน เพียงแต่เปลี่ยนตลับน้ำมันโอเลฟินส์ทุก 90 วัน และทำความสะอาดตัวเครื่องด้วยผ้าชุบน้ำเปล่าเป็นประจำ การดูแลรักษาที่ถูกต้องจะช่วยให้เครื่องสามารถป้องกันเชื้อดื้อยาได้อย่างต่อเนื่อง
สรุปบทความ
เชื้อดื้อยาเป็นภัยคุกคามทางสุขภาพที่ต้องจัดการอย่างจริงจัง การป้องกันด้วยเทคโนโลยีเครื่องฆ่าเชื้อโรคที่ทันสมัยและมีประสิทธิภาพสูง เป็นหนึ่งในวิธีการที่มีประสิทธิผลมากที่สุดในการหยุดการแพร่กระจายของเชื้อโรคดื้อยา
Wellis Air เป็นตัวอย่างที่ดีของเครื่องฆ่าเชื้อโรคที่ได้รับการรับรองจากหน่วยงานระดับสากล เช่น องค์การอาหารและยาของสหรัฐอเมริกา (US FDA), มาตรฐานความปลอดภัยของสหภาพยุโรป (CE Certificate) รวมถึงการรับรองมาตรฐานผลิตภัณฑ์อุตสาหกรรม (มอก. 60335 เล่ม 2(65)-2564) ของประเทศไทย และประสิทธิภาพในการกำจัดเชื้อดื้อยา ไม่ว่าจะเป็น MRSA หรือเชื้อ COVID-19, RSV, Rotavirus, SARS, MERS, ไข้หวัดใหญ่ทุกสายพันธ์, โรคมือเท้าปาก และเชื้อโรคอื่นๆ ได้อย่างมีประสิทธิภาพ และถูกใช้งานในโรงพยาบาลหลายแห่ง โดยใช้งานได้ตลอด 24 ชั่วโมงอย่างปลอดภัยแม้มีเด็กเล็กและผู้สูงอายุอยู่ในพื้นที่
ปัจจุบัน Wellis Air ถูกนำไปใช้ในโรงพยาบาลและคลินิกหลายร้อยแห่งทั่วประเทศ รวมถึงห้องเด็กแรกเกิด ห้อง ICU และห้องผ่าตัด ซึ่งเป็นสถานที่ที่ต้องการการป้องกันเชื้อดื้อยาในระดับสูงสุด การเลือกใช้เครื่องที่ได้รับการพิสูจน์แล้วในสถานพยาบาล และการใช้งานอย่างถูกต้อง จะช่วยปกป้องคุณและครอบครัวจากภัยร้ายของเชื้อดื้อยาได้อย่างมีประสิทธิภาพสูงสุด
ติดต่อรับคำแนะนำจากผู้เชี่ยวชาญหรือเลือกซื้อ Wellis Air ได้แล้ววันนี้
Line OA: @wellisthailand
Facebook: Wellis Thailand Official
Messenger: Wellis Thailand Official
ปรึกษาผู้เชี่ยวชาญ: 081-559-8555






